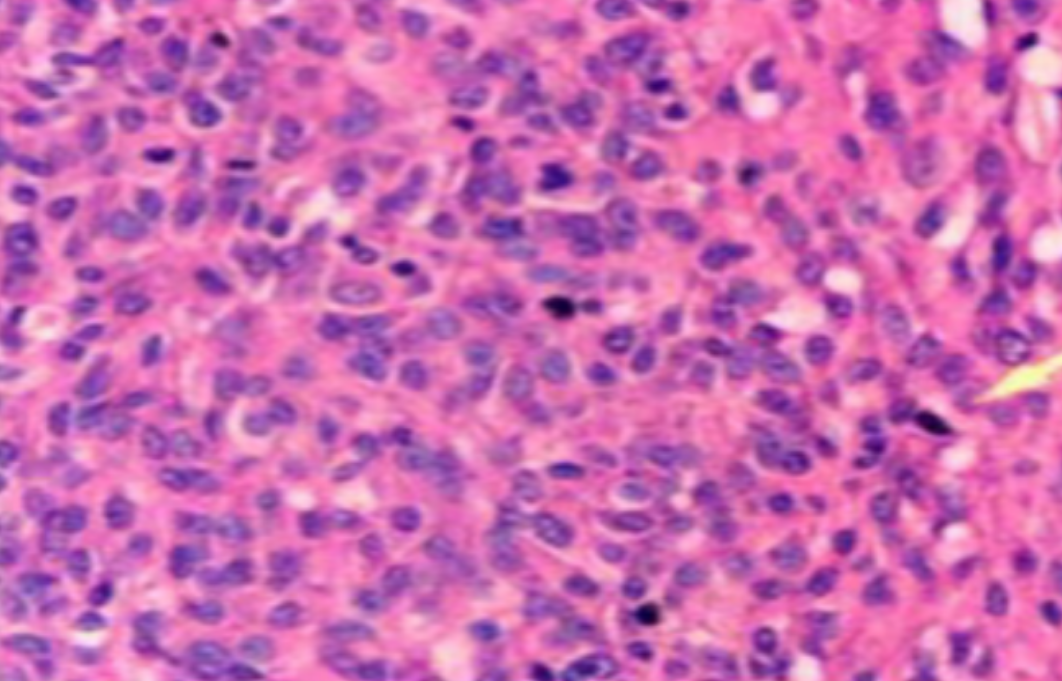
image.png

切片质量参差不齐?我们总结了15个HE染色常见问题及解决方法
发布时间:2025-11-24
浏览次数:11200
作者:东极药物
HE染色,全称苏木精-伊红染色法(Hematoxylin and Eosin staining),是最常见的组织切片染色技术之一,用于在显微镜下观察和分析组织或细胞的结构和形态。虽然HE染色是最常见且最基础的染色技术之一,😭但在实验过···
HE染色,全称苏木精-伊红染色法(Hematoxylin and Eosin staining),是最常见的组织切片染色技术之一,用于在显微镜下观察和分析组织或细胞的结构和形态。
虽然HE染色是最常见且最基础的染色技术之一,😭但在实验过程中,很容易出现各种情况导致染色切片质量参差不齐。所以,小编根据以往实验经验,给大家整理归纳出了15个HE染色中的常见问题,还包含问题原因分析以及解决方法哦~
形成原因:切片经梯度乙醇处理后没有完全脱水,导致二甲苯透明、中性树胶封固后残留大量水分。 解决方法:首先移去盖玻片,用二甲苯溶解封固剂如中性树胶,再将切片置入无水乙醇内,待切片重新脱水完全后,用二甲苯透明处理,中性树胶封固。要注意所有用于脱水和透明的液体,在使用一定时间后,应及时更换。 二、细胞核呈红、棕色 形成原因:苏木精染色液过度氧化,切片在苏木精染液染色后返蓝不足。 解决方法:每次染色之前检查苏木精染色液的染色能力,发现苏木精染色液氧化过度应及时更换。此外,切片经苏木精染色后,要给切片以足够的蓝化时间,蓝化过程可用流水、温水、弱碱性溶液(如稀氨水或0.2%碳酸氢钠)等处理。 三、切片在脱蜡后出现大片白色斑点 形成原因:由于烤(烘)片温度太低,切片上的组织蜡膜在脱蜡前没有充分烤(烘)融化。或是因为切片在二甲苯液中停留时间不足,或二甲苯使用过久,造成的脱蜡不彻底。 解决方法:若是由于切片烤(烘)温度低所致,可以先用二甲苯去除切片上的封固胶,然后重新用二甲苯脱去切片上的石蜡,再进行后续染色。若是由于切片在脱蜡的二甲苯中停留时间不足或脱蜡二甲苯使用过久浓度不足所致,则需将切片退回到二甲苯中,停留较长时间,或更换二甲苯液体重新脱蜡,再入乙醇重新脱二甲苯,入0.5%盐酸水溶液褪色后,重新HE染色。 四、细胞核苍白暗淡,即苏木精染色太淡 形成原因:切片在苏木精染色液停留时间太短;苏木精染色液过度氧化,失去染色能力,不能再继续使用;分化步骤处理时间过长;固定不及时。此外值得注意的是,若骨组织细胞核暗淡,大多是脱钙过度造成的。 解决方法:切片重新染色。如果组织在酸性固定液(如Zenker、Bouin)或非中性缓冲甲醛液固定时间过长,细胞核染色能力将减弱,需增加其在苏木精染色液的时间,或用一些方法增加组织的嗜碱性,以改善细胞核的着色。例如,上述组织玻片可以使用Weigert铁苏木精染色液。如果组织是用Zenker液固定的,可将切片脱蜡后放在5%碳酸氢钠溶液3~4h,流水冲洗5min后染色。如果组织是用Bouin液固定的,可将切片脱蜡后放在5%碳酸锂1h,流水冲洗10min后染色。 五、细胞核过染,苏木精染液占据了细胞质 形成原因:玻片在苏木精染色液停留时间过长,或是切片太厚、分化步骤时间太短。 解决方法:如果不是因为切片太厚(用显微镜仔细上下微调,只有一二层细胞核层次),就需将切片进行脱色、漂白、重新染色,适当调整染色和分化时间。但如果确定是由于切片太厚导致的细胞核过染,则需要重新切片。 六、伊红着色淡 形成原因:可能是伊红染液pH值大于5,也可能是蓝化液残留过多,切片太薄,或是切片经伊红染色后在乙醇脱水时间过长。 解决方法:检查伊红染液pH值,必要的话,用乙酸将其调节在4.6~5.0之间,从而使伊红染色色彩艳丽。此外,确保每次蓝化步骤完成后,使用的弱碱性溶液被充分洗去,玻片上没有残留的弱碱性溶液。最后,检查切片的厚度,且脱水时不要让切片在低浓度乙醇中停留时间过长,因为含水多的低浓度乙醇会将切片伊红的颜色分化掉。 七、细胞质过染、分色不足 形成原因:伊红染色液浓度太高,特别是存在焰红燃料、四溴四氯荧光素钠。切片在伊红染色时间过长,或是切片在伊红染色后经乙醇脱水步骤时时间太短,而使乙醇分化伊红的作用不能产生,都能够使细胞质过染。 解决方法:适当稀释伊红染色液,减少伊红染色时间,或使切片在乙醇脱水等步骤时,停留时间相对均匀。同样,也要检查切片的厚度是否合适。 八、切片中出现蓝黑色沉淀物 形成原因:苏木精染色液中的金属膜黏附在玻片上。 解决方法:染色前仔细过滤苏木精染色液,建议使用半氧化苏木精染色液,如Gill苏木精染色液,可以避免过多的金属膜产生。 九、光镜下切片某些区域难以聚焦 形成原因:盖玻片上可能有封固切片的封固剂。 解决方法:移去盖玻片,重新用干净的盖玻片封片。检查切片封片方法,是人工手工封法,还是机器自动封法,如有问题及时调整。 十、封固剂从盖玻片与载玻片之间的缝隙回缩 形成原因:盖玻片弯曲或不平整,或是封固剂含二甲苯过多,稀释过度。 解决方法:移去盖玻片,重新找一张盖玻片,用干净的封固剂封片。如用手工封片法,保证在封固结束时,封固剂容器盖子为紧闭状态。且尽量使用小的容器盛装封固剂,一旦封固剂太黏稠,就可以选择废弃。 十一、细胞核呈灰蓝状态 形成原因:可能由于组织处理温度过高、过热,在液体石蜡中停留的时间过长。或是固定时间太短后,直接在高浓度的乙醇中进行了脱水处理。 解决方法:理论上来说,仅在组织浸蜡步骤才进行加热,组织不能在热蜡液中停留太久。如果由于某些原因不能进行下一步包埋处理,可将组织连同塑料包埋盒一并放置在室温空气中,冷却凝固,以备包埋。待需要包埋时再重新加温直至石蜡融化即可。组织在处理前必须确保固定良好,脱水最好能从低浓度的乙醇开始。 十二、类色素的点状结晶和黑色光滑细胞核 形成原因:这种裸核改变是因为切片封片前放置在空气中的时间太长,以至于二甲苯挥发,切片干燥。 解决方法:移去组织切片上的盖玻片和封固剂,重新处理。将切片水洗数分钟,然后重新脱水、透明、封固。封片过程中要保持组织切片的轻度湿润,尽量不要让其干燥。 十三、染色过淡或过浓 解决方法:如果染色过淡,可以增加染色剂的浓度、延长染色时间或更换新鲜的染色剂;如果染色过浓,则应减少染色剂的浓度或缩短染色时间。 十四、切片出现叠加褶皱 形成原因:新购买的玻片洁净度不够、用镊子撑开切片时操作不够熟练未能平整伸展,或玻片表面有油脂,切片粘贴不牢。另外,烤片时间不足、烤片温度过低或切片过厚造成切片脱落,都会造成重叠或有皱褶的情况。 解决方法:新购买的玻片最好能用硫酸清洁液浸泡一晚,然后流水冲洗干净。在适宜的温度下烤片时间宁长勿短,保证有充足的烤片时间和温度。另外,切片刀要锋利,才能切出厚薄适宜的切片,保证切片不会因为过厚而脱落。 十五、组织残缺不全或有刮划痕迹 形成原因:组织残缺不全是由于切片时修整蜡块时深度不够、组织没有全部暴露于切面。切片的刮划痕迹是由于切片刀的刀锋有缺口、包埋的组织有异物,或是钙化组织、骨组织及包埋石蜡有沙粒造成的。 解决方法:修整蜡块时保证组织块全部暴露于切面,切片时保证切片刀的锋利没刀口。同时在组织取材时去除手术异物和钙化组织。最后,骨组织要完全脱钙,这样可以保证切片的完整和平整美观。 *注:由于实验中导致结果出现误差的原因多种多样,以上内容仅供参考,具体根据实际情况进行判断。

文章出自:验外实包 想了解更多请关注:http://www.dj-cro.com/













